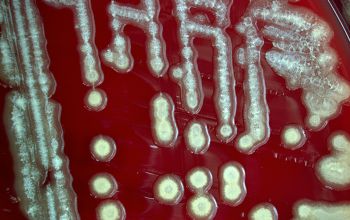

Paenibacillus pabuli
-
General information
Paenibacillus is a genus originallt included within the genus Bacillus and than reclassified as a seperate genus in 1993.
The name reflects: Latin paene means almost, so paenibacilli are literally "almost bacilli".
Taxonomy
Family: Bacillaceae
Natural habitats
Soil and feed, for cattle and other livestock
Clinical significance
Paenibacillus pabuli clinical relevance in humans is limited, and there are few documented cases of infection or disease caused by this bacterium.
In summary, while P. pabuli may have therapeutic potential, it is not widely considered a major clinical pathogen in humans.
-
Gram stain
Gram positive rods,
0.5-1.0 x 2.0-4.0 µm
gram are often negatively stained.
Spore shape: ellipsoidal
Spore position: subterminal / terminal
Sporangia swelling: positive
-
Culture characteristics
-
Facultative anaerobic
BA: colonies are grayish-white, translucent, smooth, flat, 1-2 mm after 3 days.
BBAØ: growth
-
-
Characteristics
-
References
James Versalovic et al.(2011) Manual of Clinical Microbiology 10th Edition
Karen C. Carrol et al (2019) Manual of Clinical Microbiology, 12th Edition